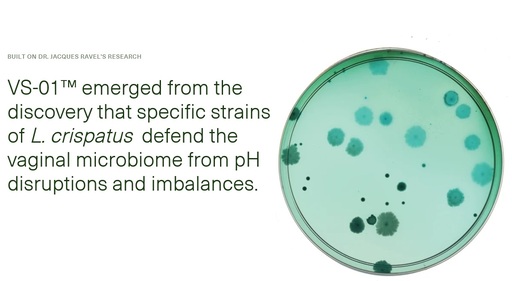
Seed VS-01 PLUS Review

Seed VS-01 PLUS Review
In partnership with Seed
Table of Contents
About Seed VS-01 PLUS
Maintaining a healthy vaginal microbiome is essential for women’s well-being, yet imbalances are frustratingly common and often poorly understood.
Seed, a science-driven company known for its innovative probiotic solutions, claims to have developed a product to directly address this: VS-01™, a vaginal synbiotic designed to restore and maintain a balanced vaginal environment. Seed’s VS-01™ is marketed as a “victory for vaginal health,” a first-of-its-kind vaginal synbiotic clinically validated to optimize the vaginal microbiome.
With a hefty price tag and promises of significant results, it’s natural to approach this product with a mix of hope and skepticism. Could this be the solution so many women have been searching for, or is it simply another overhyped product in the crowded market of women’s health?
In this comprehensive review, we’ll delve into the science behind the vaginal microbiome and its connection to overall health. You’ll be equipped with the knowledge you need to decide if Seed’s VS-01™ could be the key to unlocking a healthier, more balanced vaginal microbiome.
Highlights
- VS-01™ is the first vaginal synbiotic clinically validated to establish an optimal vaginal microbiome dominated by Lactobacillus crispatus
- It contains three proprietary Lactobacillus crispatus strains selected for their ability to strengthen vaginal stability and resilience.
- VS-01™ is formulated with a Lactobacillus-specific prebiotic complex to support the growth of beneficial bacteria.
- It utilizes a SMART Tablet™ delivery system for extended-release and optimal efficacy within the vaginal environment.
- The product is thoroughly tested for biocompatibility, allergens, contaminants, and osmolality, ensuring safety and purity.
- VS-01™ has been clinically shown to significantly increase the abundance of L. crispatus, the vagina’s most protective bacteria.
- It’s designed to address the root cause of vaginal imbalances and sustainably defend against daily disruptions.
Why You Should Trust Us?
Our mission is to help you make better, more informed purchase decisions.
Our team spends hours researching, consulting with medical experts, gathering insight from expert professionals, reviewing customer feedback, and analyzing products to provide you with the information you need.
Seed VS-01 PLUS Review
Seed VS-01™ is a first-of-its-kind vaginal synbiotic, a combination of probiotics and prebiotics designed to restore and maintain a healthy vaginal microbiome.
Delivered as two tablets monthly vaginal suppository after the Reset starter kit, VS-01™ contains three proprietary strains of Lactobacillus crispatus (LUCA103™, LUCA011™, LUCA009™), the bacteria considered the “superhero” of vaginal health. These strains are complemented by a Lactobacillus-specific prebiotic complex, which acts as nourishment, creating the ideal environment and energy source for beneficial bacteria.
The synbiotic works by directly introducing beneficial L. crispatus strains into the vaginal environment, helping to provide a growth advantage and restore balance. The prebiotic complex further supports the colonization and growth of these beneficial bacteria, creating a resilient and stable vaginal microbiome.
VS-01™ is designed for women experiencing vaginal imbalances or disruptions due to factors like menstruation, diet, stress, and certain prescription use. It’s also a suitable option for women seeking a proactive approach to maintain vaginal health and prevent future pH imbalances.
Efficacy
The efficacy of VS-01™ is supported by a randomized, double-blind, placebo-controlled clinical trial. The results were impressive: 90% of participants with a non-optimal vaginal microbiome established an optimal vaginal microbiome dominated by L. crispatus within 21 days of use. This high conversion rate demonstrates the product’s effectiveness in rapidly restoring a healthy vaginal environment.
Moreover, the trial revealed a remarkable 10x increase in L. crispatus abundance among participants using VS-01™ when compared to a leading oral probiotic product for vaginal health. This significant increase in the vagina’s most protective bacteria reinforces the product’s ability to strengthen the microbiome’s resilience against pH disruptions. Additionally, 100% of participants maintained an optimal vaginal pH throughout the study, indicating a balanced and healthy vaginal environment.
While specific research on the individual probiotic strains in VS-01™ is ongoing, Seed’s extensive research on the vaginal microbiome, led by renowned scientist Dr. Jacques Ravel, provides a strong scientific foundation for the product’s development and potential benefits.
Safety and Quality
Seed places a premium on safety and quality, particularly for a product designed for such a delicate ecosystem as the vaginal microbiome. VS-01™ undergoes rigorous testing to ensure both its safety and efficacy. This includes testing for biocompatibility using an FDA-recognized model, ensuring it won’t disrupt the vaginal epithelial barrier.
The product is also tested for 14 classes of allergens and over 500 contaminants, including heavy metals, pesticides, and other impurities. It’s formulated without any artificial fragrances, preservatives, parabens, BPAs, or phthalates. This comprehensive testing goes beyond industry standards for vaginal health products and reflects Seed’s commitment to providing safe and effective solutions.
Safety testing for vaginal health products is crucial, as the vaginal environment is highly sensitive, and harsh chemicals or imbalanced formulations can easily disrupt its delicate balance. By prioritizing rigorous testing, Seed aims to minimize the risk of adverse reactions or further imbalances caused by the product itself.
While VS-01™ is generally considered safe for use, it’s important to note that some users may experience mild discharge or discomfort upon insertion. If you have any concerns or experience any adverse reactions, it’s recommended to consult with your healthcare provider.
Comparison to Other Products
VS-01™ stands out in the market of vaginal health products due to several key factors:
- Clinical Validation. Unlike many other vaginal probiotics or synbiotics, VS-01™ has been clinically validated in a randomized, double-blind, placebo-controlled trial, demonstrating its efficacy in establishing an optimal vaginal microbiome.
- Proprietary Strains: The three proprietary L. crispatus strains in VS-01™ have been specifically selected for their ability to strengthen vaginal stability and resilience, making them unique to this product.
- Targeted Approach. VS-01™ is specifically designed to address the root cause of vaginal imbalances by directly introducing and supporting the growth of beneficial bacteria in the vaginal environment.
While oral probiotics may offer some general health benefits, they are unlikely to be as effective as VS-01™ in directly addressing the vaginal microbiome. Other vaginal health products often focus on symptom relief rather than addressing the underlying imbalance, making VS-01™ a potentially more sustainable and effective solution for long-term vaginal health.
Benefits
- Establishment of an Optimal Vaginal Microbiome. VS-01™ is clinically validated to help establish a vaginal microbiome dominated by Lactobacillus crispatus, the most protective bacteria for vaginal health.
- Increased Abundance of L. crispatus. The product has been shown to increase the abundance of L. crispatus tenfold compared to a leading oral probiotic for vaginal health
- Maintenance of Optimal Vaginal pH. VS-01™ helps maintain a balanced vaginal pH, which is crucial for a healthy vaginal environment.
- Reduced Vaginal Imbalances. By restoring and maintaining a healthy microbiome, VS-01™ can help support a healthy bacteria and yeast balance
- Proactive Vaginal Health. VS-01™ can be used not only to address existing imbalances but also as a preventative measure to maintain a healthy vaginal microbiome and protect against future pH disruptors.
- Healthy Yeast Balance: VS-01™ is clinically validated to promote/maintain/sustain a healthy balance of yeast and bacteria in the vagina/vaginal tract
How to use VS-01™ Vaginal Synbiotic?
- Start Time:
- If you have regular periods: Start immediately after your period ends (spotting is okay).
- If you have irregular periods or don’t menstruate: Start at any time.
- If irregular bleeding occurs during use: Resume using VS-01™ once bleeding stops.
- Insertion:
- Place one VS-01™ tablet into the provided applicator.
- Insert the applicator into your vagina and push the inner tube to release the tablet (similar to inserting a tampon).
Additional Notes:
- Monthly Use: Continue using VS-01™ monthly to maintain a healthy vaginal microbiome.
- Lubrication: VS-01™ relies on your body’s natural lubrication to dissolve, so it may not be as effective if you experience significant vaginal dryness.
- Consultation: If you have any concerns or questions about using VS-01™, consult your healthcare provider.
Price
Seed VS-01™ is offered in a 2-month starter kit for $99, which includes enough tablets for the initial “reset” phase (six tablets for the first month) and the ongoing “sustain” phase (two tablets per month).
Following the starter kit, a monthly subscription is available for $39.99, providing two tablets per month for continued maintenance and protection against disruptions.
The first month, or “reset” phase, involves using one VS-01™ tablet daily to rapidly establish an optimal vaginal microbiome. After the initial reset, the “sustain” phase begins in the second month and beyond, where you’ll use two tablets per month to maintain the balanced microbiome and protect against pH disruptors.
Seed offers free shipping within the US and provides the flexibility to manage or cancel your subscription at any time. While currently available in the US, Seed is actively working to expand access to VS-01™ internationally. You can join their waitlist for updates on availability in your region.
It’s worth noting that VS-01™ is eligible for reimbursement through Health Savings Accounts (HSA) and Flexible Spending Accounts (FSA), although it’s always wise to confirm with your plan administrator for specific details.
Seed VS-01 PLUS Review: What Do Customers Think?
Users of Seed’s VS-01™ have reported a range of positive experiences. Many have noticed improvements in their vaginal health within a few weeks of use, with more significant results becoming evident after a month. This suggests that VS-01™ may offer relatively quick relief for some, while others may need a bit more time to experience its full benefits.
Another common theme in user feedback is a reduced worry and anxiety surrounding vaginal health. People using VS-01™ report feeling less concerned about potential disruptions to their vaginal microbiome, indicating that the product may provide a sense of security and confidence in maintaining vaginal balance.
Many users describe a newfound sense of normalcy after using VS-01™. They report feeling less aware of their vaginas, with a decrease in the discomfort that previously required constant attention. This suggests that VS-01™ may help alleviate symptoms and allow women to focus less on their vaginal health and more on their daily lives.
Here is the feedback:
“I noticed results in a few weeks of use, with more significant results after 1 month of use.”
“Since starting VS-01™, I’m not as worried about the potential of disrupting my vagina.”
“Sometime during the first week, I realized I was no longer aware of my vagina. Which sounds funny, but not noticing my vagina was actually amazing.”
“For me, it was more about not noticing things that were common and disruptive to my day. I was having to put a lot of unnecessary attention to those things before.”
Sara Gottfried, MD, a Harvard-trained gynecologist, believes that VS-01™ is a significant advancement in women’s health, particularly in addressing the role of the microbiome in reproductive and postpartum care.
Erica Chidi, an author and health educator, views VS-01™ as a revolutionary product, providing a scientifically-backed solution for women to protect and maintain their vaginal health.
Is Seed Legit?
Seed is a legitimate company with a strong commitment to scientific research and transparency. Their products, including VS-01™, are backed by clinical studies and formulated with well-researched probiotic strains. They also prioritize sustainability and ethical practices in their business operations.
Is Seed VS-01 PLUS Worth It?

Seed VS-01™ is a resounding YES for women seeking a scientifically-backed, clinically-validated solution to restore and maintain vaginal health. Its targeted approach, backed by rigorous research, addresses the root cause of imbalances, setting it apart from superficial solutions.
While the investment may seem steep, the potential benefits of a healthier, more balanced vaginal microbiome, as evidenced by glowing user reviews, are priceless. Address the source, not the symptoms with VS-01™ and experience the confidence and comfort of a truly thriving vaginal ecosystem.
Seed Discount & Promotions
Seed offers two main discount programs:
- Verified Discount Program
- Eligibility: Nurses, doctors, students, teachers, first responders, and military veterans.
- How to Apply: Select your status during checkout and follow the prompts for verification.
- Discount: The specific discount amount is not stated, but it’s a verified discount, so it’s likely a significant percentage off.
- Limited-Time Promotion
- Discount: 25% off the VS-01™ 2-month starter kit.
- How to Apply: Submit your email address to receive a code.
- Note: By submitting your email, you consent to receive marketing emails from Seed.
- HSA/FSA Eligible
- You can purchase VS-01™ using your HSA or FSA debit card at checkout. Check with your plan administrator as specific approval may vary by carrier.
Additionally, Seed mentions on their website that they offer free shipping within the US.
Where Can I Buy Seed’s VS-01?

Seed’s VS-01™ is available exclusively on Seed’s website at seed.com/vaginal-synbiotic.
You can purchase the 2-month starter kit or subscribe to the monthly delivery option. Seed offers free shipping within the US and also has a verified discount program for nurses, doctors, students, teachers, first responders, and military veterans.
FAQ
Who can benefit from VS-01™?
VS-01™ is ideal for adults between 18 and 55 who are experiencing vaginal imbalances or want to proactively protect their vaginal health. However, if you experience significant vaginal dryness, it’s best to consult your doctor as VS-01™ might not be as effective in such cases.
Is VS-01™ safe to use?
Yes, VS-01™ boasts a robust safety profile, thanks to extensive clinical testing on humans and preclinical testing in laboratories. It’s meticulously checked for impurities and allergens, and is formulated with gentle, non-irritating ingredients that have been proven safe and compatible with the delicate vaginal environment.
How long can I take VS-01™?
VS-01™ is designed for continuous use to quickly establish and maintain a healthy vaginal microbiome that is less susceptible to everyday disruptions. It has undergone rigorous third-party testing and is safe for long-term use, making it a sustainable solution for ongoing vaginal health.
Can I use VS-01™ during my period?
It’s recommended to avoid using VS-01™ during moderate to heavy bleeding to ensure optimal dissolution and absorption. However, you can use it during light bleeding or spotting. If your cycle is irregular, simply continue use as close to the schedule as possible.
How do I contact Seed?
Seed’s dedicated customer support team is ready to assist you. You can reach them by phone at 844-646-3586 or by emailing [email protected].
Their website also features a “Help” section where you might find answers to other questions you may have.
If you’re looking for other awesome health brands check out Ritual Vitamins, Persona Nutrition, and Neuriva.

Ask the community or leave a comment
WRITE A REVIEWCustomer Reviews
Leave a review